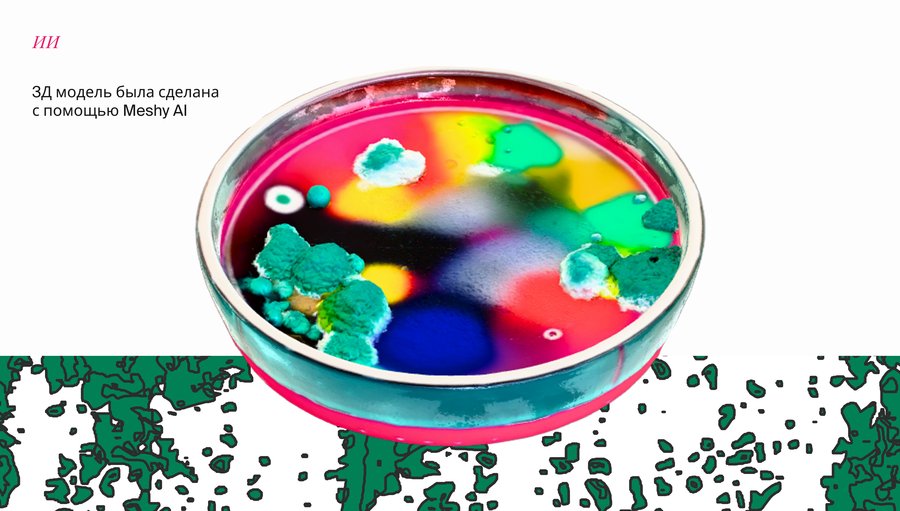
big

Ищете неповторимый акцент для вашего интерьера? Позвольте нашей плесени стать живым произведением искусства, постоянно эволюционирующим и преображающим пространство вашего дома. Каждый день новые формы, новые оттенки, новая история. И будьте спокойны: этот уникальный био-декор совершенно безвреден и безопасен для всех обитателей, от человека до самых маленьких питомцев!